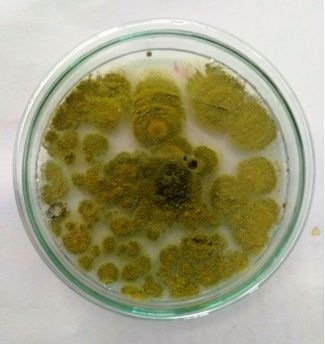

Bread-mold fungus
 Sep 06, 2019 • 4:24 AM UTC
Sep 06, 2019 • 4:24 AM UTC Unknown Location
Unknown Location 140x Magnification
140x Magnification Microorganisms
Microorganisms
Soumitra Banerjee
Learn about the author...
9posts
0comments
1locations

View in Media Gallery
Vidya GA; Sharanya Rao* and Soumitra Banerjee
CIIRC-Jyothy Institute of Technology, Bangalore, Karnataka
*Manipal Institute of Technology, Manipal (Karnataka)
The molds on bread were taken and cultured it on the potato dextrose agar media. Spores on the media were observed under foldscope. The mold spreads quickly and the entire bread turns into a green or black color. Bread mold is a simple fungus that takes food and nutrients from the bread and damages the bread surface. Mold growing on the bread can be microscopic fungi belonging to different species like Penicillium, Rhizopus, Aspergillus, Monascus and Fusarium. They are of different shapes and colors depending on the species. Rhizopus stolonifer is the most common and fast growing bread mold. It is also known as black mold as it appears dark green or black in color.
CIIRC-Jyothy Institute of Technology, Bangalore, Karnataka
*Manipal Institute of Technology, Manipal (Karnataka)
The molds on bread were taken and cultured it on the potato dextrose agar media. Spores on the media were observed under foldscope. The mold spreads quickly and the entire bread turns into a green or black color. Bread mold is a simple fungus that takes food and nutrients from the bread and damages the bread surface. Mold growing on the bread can be microscopic fungi belonging to different species like Penicillium, Rhizopus, Aspergillus, Monascus and Fusarium. They are of different shapes and colors depending on the species. Rhizopus stolonifer is the most common and fast growing bread mold. It is also known as black mold as it appears dark green or black in color.

View in Media Gallery
Fig. 1 Spoiled bread – Fungal infestation
View in Media Gallery
Fig. 2. Fungal growth observed under nutrient agar

View in Media Gallery
Fig. 3 Bread mould observed under foldscope
Sign in to commentNobody has commented yet... Share your thoughts with the author and start the discussion!

 0 Applause
0 Applause 0 Comments
0 Comments





